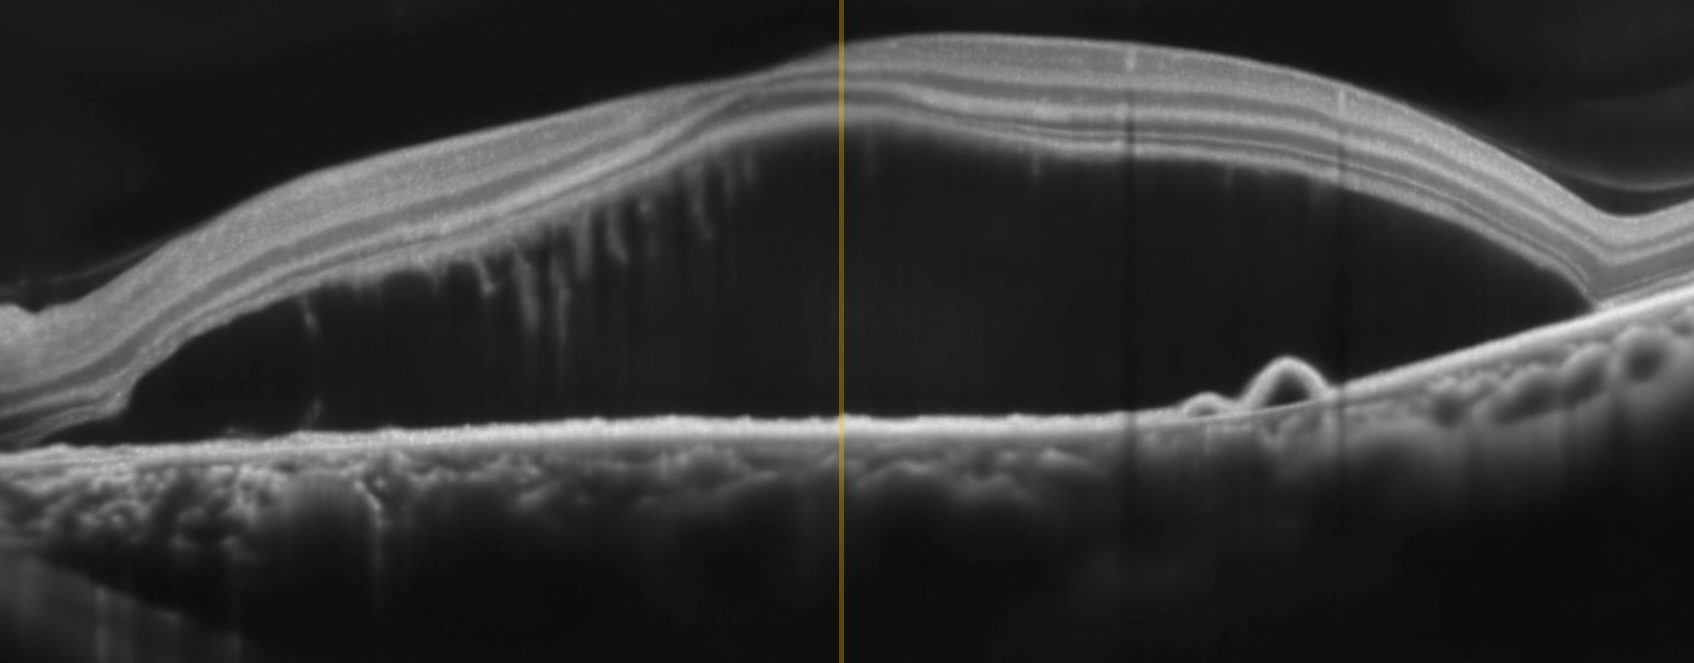
Before

Vitreoretinal Services
At Narang Netralaya, our Vitreoretinal Department is dedicated to delivering cutting-edge care for disorders affecting the retina and vitreous. With world-class diagnostic tools, advanced laser systems, and state-of-the-art surgical technology, we provide comprehensive management of both common and complex retinal diseases.
Our retina unit is led by a skilled vitreoretinal surgeon, Dr Madhushmita, offering personalized, evidence-based treatment with a strong focus on patient comfort, safety, and visual outcomes.
MEET OUR VITREORETINA SURGEON:
Dr. Madhushmita Narang
Vitreoretinal Surgeon | Fellowship Trained at LV Prasad Eye Institute (LVPEI).
Dr. Narang did her MBBS from RGUHS, Bangalore, and MS (Ophthalmology) from DMC, Ludhiana. She secured 1st Rank in her MS exam in Punjab state.
Dr. Madhushmita Narang is a highly skilled and dedicated vitreoretinal surgeon with advanced fellowship training from the prestigious LV Prasad Eye Institute (LVPEI)—one of the world’s leading centres for retinal care and research.
Her 3-year intensive surgical and clinical training equips her to diagnose and treat both simple and highly complex retinal disorders with precision.
With a patient-centric approach and a strong foundation in evidence-based retinal care, Dr. Madhushmita Narang is committed to delivering the highest quality outcomes for every patient.
Dr. Madhushmita is known for her empathetic communication, clear guidance, and ethical practice. She ensures that every patient understands their condition, treatment options, and expected outcomes.
Her commitment is simple:
“Deliver the highest standard of retinal care with compassion, clarity, and modern technology.”
1. Advanced Retinal Diagnostic Suite
Accurate diagnosis is the foundation of successful retinal care. Our centre is equipped with the latest imaging modalities to detect and monitor retinal diseases with unparalleled precision.
NIDEK DUO 2 OCT

- High-resolution optical coherence tomography for detailed cross-sectional imaging of retinal layers
- Essential for diagnosing macular holes, diabetic macular edema, ERM, AMD, and many other conditions
- Provides rapid, non-invasive scans for precise follow-up
Autofluorescence Imaging
- Detects early changes in the retinal pigment epithelium
- Helps identify retinal dystrophies, macular degeneration, and subtle pathology not visible on routine examination.
Colour Fundus Photography
- High-quality pictures of the retina
- Useful for documentation, patient education, and long-term monitoring
Ultrasound BScan
- The Appasamy B-Scan is a high-resolution ocular ultrasound that provides clear retinal imaging even when the view is obstructed by cataract, corneal opacity, or vitreous hemorrhage. It helps accurately diagnose conditions like retinal detachment, vitreous pathology, and oculor trauma. This technology enhances clinical decision-making and supports precise surgical planning in our retino department

Together, these imaging systems allow us to detect diseases early, plan accurate treatment, and track response to therapy effectively.
2. Advanced Retinal Laser Treatments

Our centre features the Zeiss Multispot Green Laser (PASCAL) – one of the most advanced retinal laser platforms available today.
Benefits of PASCAL Multispot Laser
- Faster treatment with less discomfort
- Highly precise and customizable laser patterns
- Reduced collateral retinal damage
- Safer and more uniform laser burns
Laser Procedures Offered
- Panretinal photocoagulation (PRP) for proliferative diabetic retinopathy
- Focal/Grid laser for diabetic macular edema
- Retinopexy (barrage laser) for retinal tears and lattice degeneration
- Laser for venous occlusions and other vascular disorders
- Laser for selected macular pathologies
3. Intravitreal Injection Services
We provide safe, sterile, and protocol-driven administration of all major intravitreal injections, including anti-VEGF agents and intravitreal steroids.
Conditions Treated
- Wet age-related macular degeneration (AMD)
- Diabetic macular edema
- Retinal vein occlusion (RVO)
- Myopic CNVM
- Endophthalmitis
- Other macular and retinal vascular disorders
Why Patients Prefer Our Injection Units
- Strict aseptic technique
- High-quality drugs sourced from trusted suppliers
- Comfortable injection rooms
- Detailed counselling about drug choice, risks, and follow-up
4. Comprehensive Retina Surgery Facilities
Our vitreoretinal surgery department is equipped to handle both routine and complex cases with precision and safety.
Constellation® Vision System

- Industry-leading vitrectomy machine by Alcon
- High cut-rate vitrectomy for safer, smoother surgeries
- Enhanced fluidics for complex retinal detachments


Zeiss Lumera I Microscope with Resight Systemem
- Wide-angle viewing with exceptional clarity
- Superior visualization of retina and vitreous structures
- Improves surgical safety and precision
Retinal Surgeries We Perform
- Pars plana vitrectomy for retinal detachment
- Macular hole surgery
- Epiretinal membrane (ERM) peeling
- Vitrectomy for vitreous hemorrhage
- Diabetic tractional retinal detachment surgery
- Endolaser, gas tamponade, silicone oil procedures
- Management of ocular trauma and intraocular foreign bodies
- Combined cataract + retina surgeries when required
Conditions We Treat
We offer complete management of:
- Diabetic retinopathy
- Wet & dry age-related macular degeneration
- Retinal vein occlusions
- Retinal detachment
- Macular hole
- Epiretinal membrane
- Vitreous hemorrhage
- Central serous chorioretinopathy
- Inherited retinal diseases
- Posterior uveitis
- Trauma-related retinal disorders
Why Choose Our Retina Department?
- Latest technology for diagnosis and surgery
- Skilled and compassionate vitreoretinal surgeon
- Evidence-based treatment protocols
- Transparent counselling and clear communication
- Patient-friendly approach with personalized follow-up
- Sterile, well-equipped procedure rooms
- Ethical practice with focus on long-term visual outcomes
Our Commitment to Patients
We understand that retinal diseases can be visually and emotionally challenging. Our team is committed to:
- Providing timely diagnosis
- Offering the most advanced treatment available
- Ensuring your comfort and safety at every step
- Keeping you informed and empowered throughout your care
- Your vision is our priority.
Frequently Asked Questions
What is the retina and why is it important for vision?
The retina is a thin, light-sensitive layer at the back of the eye. It works like a camera film, capturing images and sending them to the brain. Any damage to the retina can result in blurred vision or even permanent vision loss if not treated in time.
What symptoms need urgent retina check-up?
Sudden floaters, flashes, blurred vision, or a dark curtain in your sight.
What tests are done for retina problems?
OCT scan, Retinal Photography, FFA, and B-Scan.
What are common retina diseases?
Diabetic Retinopathy, Retinal Detachment, Macular Hole, ERM, Vitreous Hemorrhage.
Are retinal diseases treatable?
Most retinal diseases are treatable if detected early. Treatment options include laser therapy, intravitreal injections, vitrectomy surgeries, medications, and sometimes observation depending on the condition.
Is retinal detachment an emergency?
Yes. It needs immediate treatment to save vision.
What is vitrectomy surgery?
A minimally invasive surgery to treat retinal diseases by removing the vitreous gel.
Is retina surgery painful?
No. It is done under local or general anesthesia.
How long is the recovery after retina surgery?
Most patients recover in 4–6 weeks, depending on the condition. It may take 6-1 year to know the final visual outcome
Can diabetic patients lose vision without symptoms?
Yes. Diabetes can silently damage the retina. Yearly eye check-ups are essential.
What are intravitreal injections (Anti-VEGF)?
Anti-VEGF injections are medicines injected inside the eye to reduce swelling and abnormal blood vessel growth. They are commonly used in diabetic macular edema, ARMD, vein occlusion, and many other retinal conditions.
What is retina laser treatment?
Retinal laser is a painless outpatient procedure used to seal weak areas of the retina, stop abnormal vessels, or prevent further damage in diabetic retinopathy and retinal tears.
Who performs retina surgery at your hospital?
Dr. Madhushmita Narang, LVPEI-trained retina specialist with 5000+ injections & 1000+ surgeries.
ERM SURGERY


DME ANTI-VEGF INJECTION


CSCR

RETINA DETACHMENT


MACULAR HOLE SURGERY


Opening Hours
Narang Netralaya is one of Jalandhar’s most trusted eye care centres, offering advanced treatments with a patient-first approach.
- Visit Our Hospital 267, Mota Singh Nagar, Jalandhar, Punjab
- Contact Us +91 83600 84901


